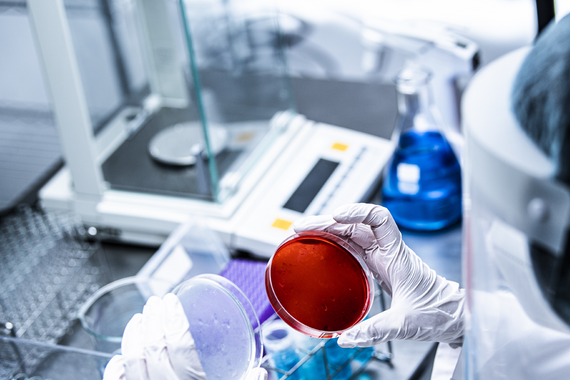

-
The University
- Welcome
- Who we are
- Media & PR
-
Studying
- General
- Degree programs
- Campus life
-
Research
- Profile
- Infrastructure
- Cooperations
- Services
-
Career
- Med Uni Graz as an Employer
- Educational Opportunities
- Work Environment
- Job openings
-
Diagnostics
- Patients
- Referring physicians
- Health Topics
- Health Infrastructure
Research centers & institutes
Teaching, research and diagnostics are carried out according to the biopsychosocial model in three basic research centers and four unaffiliated institutes. The scope and the content of the research centers are organized to optimally exploit the research potential and to achieve high visibility within the university and outside it. The growing specificity of the research profile makes the research centers increasingly attractive partners for (clinical) researchers within Med Uni as well as for regional, Austrian, European and global cooperation and networks. The essential tasks of the research centers remain high-quality research-driven teaching and specialized training in the individual disciplines.
Otto Loewi Research Center
At the Otto Loewi Research Center for Vascular Biology, Immunology and Inflammation, four divisions pool their competences in research and studies.

Gottfried Schatz Research Center
At the Gottfried Schatz Research Center for Cell Signaling, Metabolism and Aging, four divisions pool their competences in research and studies.

Diagnostic and Research Center
At the Diagnostic and Research Center for Molecular Biomedicine, four institutes pool their competences in research and studies.

Unaffiliated institutes
In four unaffiliated institutes, teaching and research are conducted according to the biopsychosocial model.


